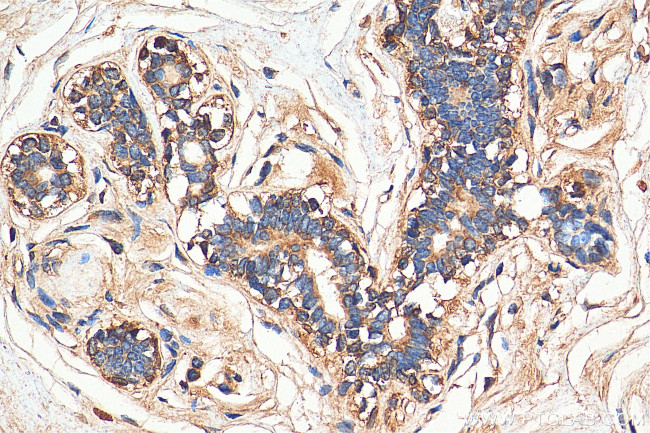
MRP1 Antibody in Immunohistochemistry (Paraffin) (IHC (P))

Search
Proteintech
MRP1 Polyclonal Antibody
{{$productOrderCtrl.translations['antibody.pdp.commerceCard.promotion.promotions']}}
{{$productOrderCtrl.translations['antibody.pdp.commerceCard.promotion.viewpromo']}}
{{$productOrderCtrl.translations['antibody.pdp.commerceCard.promotion.promocode']}}: {{promo.promoCode}} {{promo.promoTitle}} {{promo.promoDescription}}. {{$productOrderCtrl.translations['antibody.pdp.commerceCard.promotion.learnmore']}}
产品信息
27825-1-AP
种属反应
宿主/亚型
分类
类型
抗原
偶联物
形式
纯化类型
保存液
内含物
保存条件
运输条件
产品详细信息
Immunogen sequence: SSYSGDISRH HNSTAELQKA EAKKEETWKL MEADKAQTGQ VKLSVYWDYM KAIGLFISFL SIFLFMCNHV SALASNYWLS LWTDDPIVNG TQEHTKVRLS VYGALGIS
靶标信息
The protein encoded by this gene is a member of the superfamily of ATP-binding cassette (ABC) transporters. ABC proteins transport various molecules across extra-and intra-cellular membranes. ABC genes are divided into seven distinct subfamilies (ABC1, MDR/TAP, MRP, ALD, OABP, GCN20, White). This full transporter is a member of the MRP subfamily which is involved in multi-drug resistance. This protein functions as a multispecific organic anion transporter, with oxidized glutathione, cysteinyl leukotrienes, and activated aflatoxin B1 as substrates. This protein also transports glucuronides and sulfate conjugates of steroid hormones and bile salts. Alternative splicing by exon deletion results in several splice variants but maintains the original open reading frame in all forms.
仅用于科研。不用于诊断过程。未经明确授权不得转售。
篇参考文献 (0)
生物信息学
蛋白别名: ATP-binding cassette sub-family C member 1; ATP-binding cassette transporter variant ABCC1delta-ex13&14; ATP-binding cassette transporter variant ABCC1delta-ex25&26; ATP-binding cassette, sub-family C (CFTR/MRP), member 1; DKFZp686N04233; DKFZp781G125; glutathione S-conjugate export pump; Glutathione-S-conjugate-translocating ATPase ABCC1; leuk; Leukotriene C(4) transporter; LTC4 transporter; Multidrug resistance-associated protein 1
基因别名: ABC29; ABCC; ABCC1; DFNA77; GS-X; MRP; MRP1
UniProt ID: (Human) P33527
Entrez Gene ID: (Human) 4363